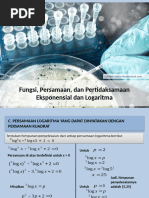

0% found this document useful (0 votes)
47 views13 pagesMa2 Modul1
Dokumen ini membahas tentang fungsi transcendental seperti fungsi logaritma alami, fungsi invers, dan fungsi eksponensial alami. Dokumen ini menjelaskan definisi, sifat-sifat, turunan, dan integral dari ketiga fungsi tersebut beserta contoh soalnya.
Uploaded by
Nugraha catur Septian patraCopyright
© © All Rights Reserved
We take content rights seriously. If you suspect this is your content, claim it here.
Available Formats
Download as PDF, TXT or read online on Scribd
0% found this document useful (0 votes)
47 views13 pagesMa2 Modul1
Dokumen ini membahas tentang fungsi transcendental seperti fungsi logaritma alami, fungsi invers, dan fungsi eksponensial alami. Dokumen ini menjelaskan definisi, sifat-sifat, turunan, dan integral dari ketiga fungsi tersebut beserta contoh soalnya.
Uploaded by
Nugraha catur Septian patraCopyright
© © All Rights Reserved
We take content rights seriously. If you suspect this is your content, claim it here.
Available Formats
Download as PDF, TXT or read online on Scribd